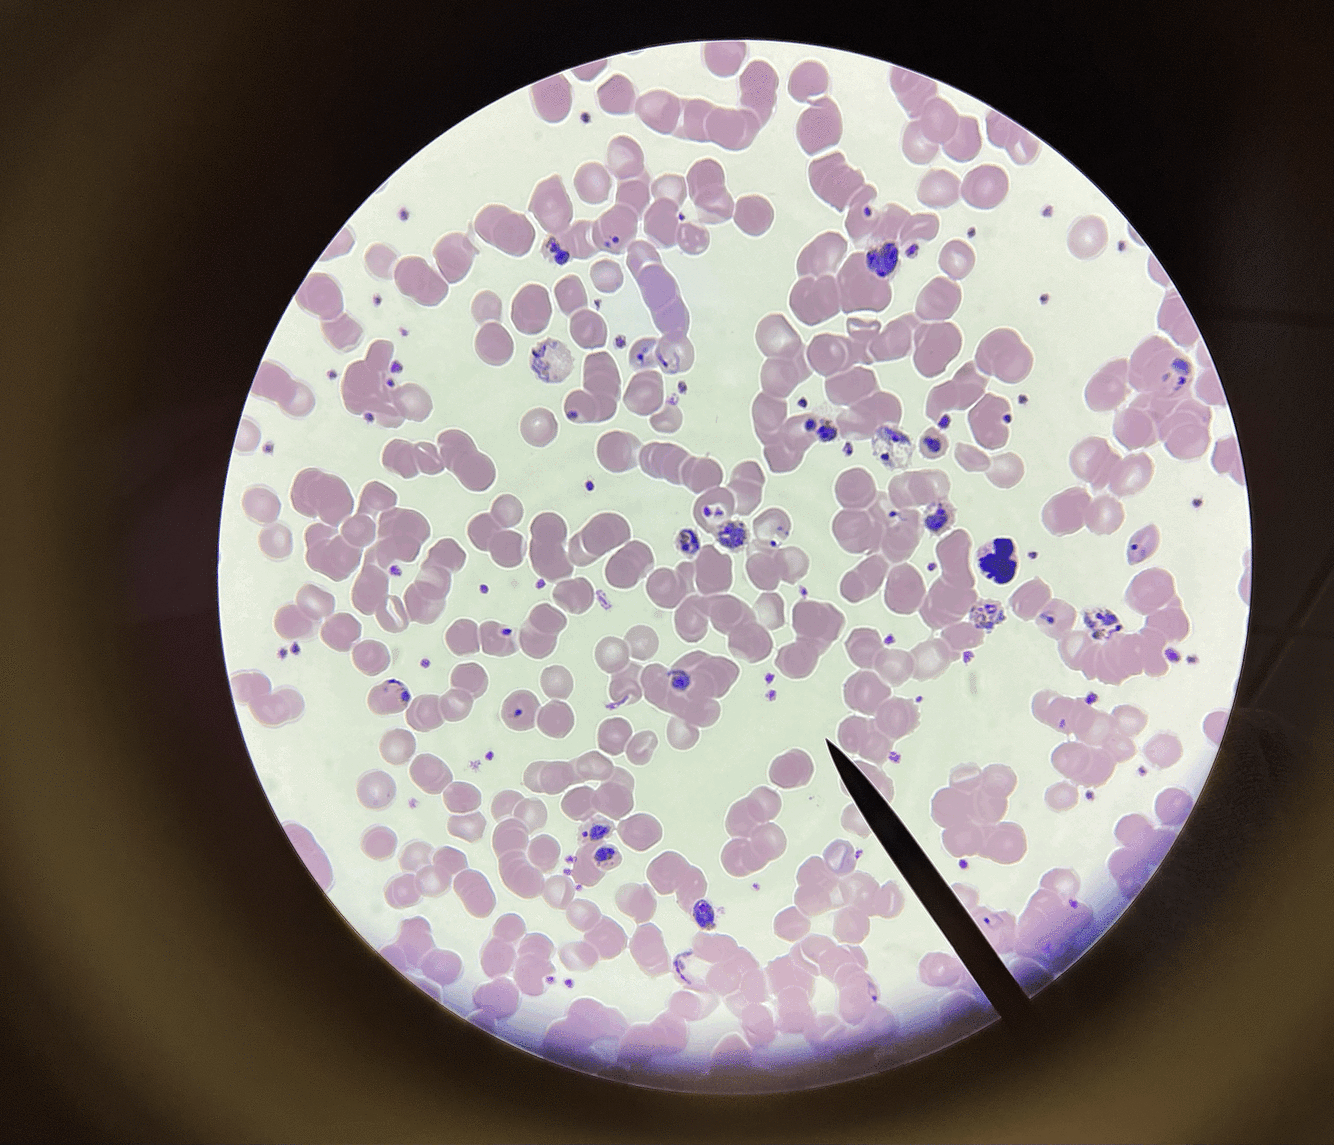

What is the genus, phylum, and kingdom?

Genus: Pelomyxa Phylum: Archaeprotista (Protozoa) Kingdom: Protista Shape: giant flagellar amoebae Where are they from: freshwater ponds or slow-moving streams
What is the genus, phylum, and kingdom?

Genus: Giardia
Phylum: Archaeprotista (Protozoa)
Kingdom: Protista
Where do they come from: contaminated food or water or person-to-person contact
What is the genus, phylum, kingdom?

Genus: Amoeba (Turtox chart)
Phylum: Rhizopoda (Protozoa)
Kingdom: Protista
Shape: Ability to alter its shape
What is the genus, phylum, kingdom?

Genus: Foraminifera (Turtox chart)
Phylum: Foraminifera (Protozoa)
Kingdom: Protista
Shape: External shell
What is the genus, phylum, kingdom?

Genus: Radiolaria (Turtox chart)
Phylum: Actinopoda (Protozoa)
Kingdom: Protista
Shape: Elaborate mineral skeleton
What is the genus, phylum, kingdom?

Genus: Paramecium (Turtox chart)
Phylum: Ciliophora (Protozoa)
Kingdom: Protista
Shape: Resembles the sole of a shoe
What is the genus, phylum, kingdom?

Genus: Stentor (Turtox chart)
Phylum: Ciliophora (Protozoa)
Kingdom: Protista
Shape: Horn-shaped
What is the genus, phylum, kingdom?

Genus: Euglena (Turtox chart)
Phylum: Discomitochondria (Protozoa)
Kingdom: Protista
Shape: Single cell flagellate
What is the genus, phylum, and kingdom?

Genus: Trypanosoma (Turtox chart)
Phylum: Discomitochondria (Protoza)
Kingdom: Protista
Shape: Parasitic flagellate
What is the genus, phylum, kingdom?
Genus: Plasmodium (Turtox chart)
Phylum: Apicomplexa (Protozoa)
Kingdom: Protista
Shape: Parasites of vertebrate and insects
What is the genus, phylum, and kingdom?

Genus: Gregarina
Phylum: Apicomplexa (Protozoa)
Kingdom: Protista
What is it: Large parasite inhabit the intestines
What is the genus, phylum, and kingdom?

Genus: Ceratium (Turtox chart)
Phylum: Dinomastigota (Algae)
Kingdom: Protista
Shape: Dinoflagellates
What is the genus, phylum, and kingdom?

Genus: Peridinium
Phylum: Dinomastigota (Algae)
Kingdom: Protista
Shape: Armoured dinoflagellates
What is the genus, phylum, and kingdom?

Genus: Diatoms (Turtox chart)
Phylum: Bacillariophyta (Algae)
Kingdom: Protista
Shapes: Circular, triangular, square, and elliptical
What is the genus, phylum, and kingdom?

Genus: Synura
Phylum: Chrysomonada (Algae)
Kingdom: Protista
Found: In the plankton of freshwater lakes, ponds, rivers
What is the genus, phylum, and kingdom?
Genus: Kelp (Specimen)
Phylum: Phaeophyta (Algae)
Kingdom: Protista
Shape: Blades are similar to the leaves on land plants
What is the genus, phylum, kingdom?

Genus: Laminaria
Phylum: Phaeophyta (Algae)
Kingdom: Protista
Shape: Long and flat blades
What is the genus, phylum, and kingdom?

Genus: Fucus (Turtox chart)
Phylum: Phaeophyta (Algae)
Kingdom: Protista
Shape: Mucilage-covered blades
What is the genus, phylum, and kingdom?

Genus: Polysiphonia
Phylum: Rhodophyta (Algae)
Kingdom: Protista
Shape: Filamentous red algae
What is the genus, phylum, and kingdom?

Genus: Chlamydomonas
Phylum: Chlorophyta (Algae)
Kingdom: Protista
Shape: Unicellular flagellates
What is the genus, phylum, and kingdom?

Genus: Gonium (Turtox chart)
Phylum: Chlorophyta (Algae)
Kingdom: Protista
Shape: Colonial algae
What is the genus, phylum, kingdom?

Genus: Pandorina (Turtox chart)
Phylum: Chlorophyta (Algae)
Kingdom: Protista
Shape: Sack globular colony
What is the genus, phylum, and kingdom?

Genus: Volvox (Turtox chart)
Phylum: Chlorophyta (Algae)
Kingdom: Protista
Shape: Spherical colonies
What is the genus, phylum, kingdom?

Genus: Volvox (Turtox chart)
Phylum: Chlorophyta (Algae)
Kingdom: Protista
Shape: Spherical colonies






